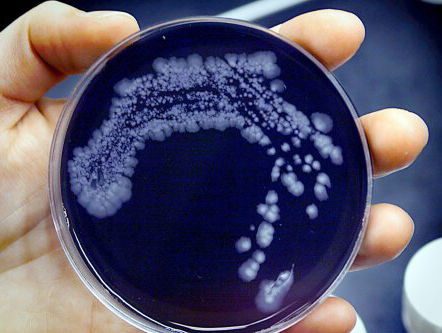
Stijging in het aantal legionella besmettingen

Fragmenten
Open Huis
- Programma's
- Open Huis
- Fragmenten
Vlinders in nood, maar we kunnen ze helpen!
Tips van SeniorWeb voor fotograferen met je smartphone
Verscheurde tekeningen Fiep Westendorp tentoongesteld
Portret taalambassadeur Lenie
Stijging in het aantal legionella besmettingen
Nationale Spinnentelling in huis en tuin
Hoe zit dat? "Houdoe!"
Langer leven met een bruine boterham
Portret taalambassadeur
3 van 3: Fysiek en mentaal bezig blijven is belangrijk bij het ouder worden
2 van 3: Ikaria leerde Erik Scherder het belang van matigheid
1 van 3: Erik Scherder gaat op zoek naar het geheim van Methusalem